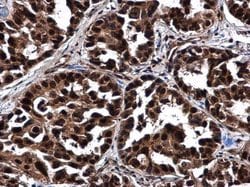
Invitrogen NOP56 Polyclonal Antibody 100 &mu;L; Unconjugated:Antibodies,

missing translation for 'onlineSavingsMsg'
Learn More
Learn More
Invitrogen™ NOP56 Polyclonal Antibody


Rabbit Polyclonal Antibody
Brand: Invitrogen™ PA578329
This item is not returnable.
View return policy
Description
Positive Control: 293T, A431, HeLa, HepG2 Predicted Reactivity: Chimpanzee (95%) Store product as a concentrated solution. Centrifuge briefly prior to opening the vial.
ErbB 4 (Her-4, c-erbB-4, v-erbB-4) is a member of the class I receptor kinase family. With more than 500 gene products, the protein kinase family is one of the largest families of proteins in eukaryotes. The family has been classified in 8 major groups based on sequence comparison of their tyrosine (PTK) or serine/threonine (STK) kinase catalytic domains. ErbB 4 is activated by neuregulins and NTAK (neural and thymus derived activator for ErbB kinases). ErbB 4 is a receptor for heregulin and is capable of mediating HGL-stimulated tyrosine phosphorylation of itself. Like other protein kinases, ErbB 4 mediate most of the signal transduction in eukaryotic cells, regulating cellular metabolism, transcription, cell cycle progression, cytoskeletal rearrangement and cell movement, apoptosis, and differentiation. ErbB 4 is most predominantly expressed in several breast carcinoma cell lines, and in normal skeletal muscle, heart, pituitary, brain, and cerebellum. Breast tumor cell lines T47-D, MDA-MB-453, BT-474 and H3396 are found to have the highest levels of mRNA, and intermediate levels are seen in MCF-7, MDAMB-330 and MDA-MB-361. Expression of ErbB 4 is low or absent in some breast tumor cell lines such as MDA-MB-231, MDA-MB-157, MDA-MB-468, and SKBR-3. ErbB 4 levels have been found to be elevated in certain human tumor cell lines suggesting that it may play a role in some malignancies.
Specifications
| NOP56 | |
| Polyclonal | |
| Unconjugated | |
| Nop56 | |
| 2310044F10Rik; 56kDa with KKE/D repeat; hypothetical protein 1195; NOL5A; Nop56; NOP56 ribonucleoprotein; NOP56 ribonucleoprotein homolog; nucleolar protein 56; Nucleolar protein 5A; nucleolar protein 5A (56kDa with KKE/D repeat); SCA36; similar to nucleolar protein 5A (56kDa with KKE/D repeat) | |
| Rabbit | |
| Antigen affinity chromatography | |
| RUO | |
| 10528 | |
| Store at 4°C short term. For long term storage, store at -20°C, avoiding freeze/thaw cycles. | |
| Liquid |
| Immunohistochemistry (Paraffin), Immunoprecipitation, Western Blot, Immunocytochemistry | |
| 0.54 mg/mL | |
| PBS with 20% glycerol and 0.025% ProClin 300; pH 7 | |
| O00567 | |
| Nop56 | |
| Recombinant protein encompassing a sequence within the C-terminus of human NOL5A. The exact sequence is proprietary. | |
| 100 μL | |
| Primary | |
| Human | |
| Antibody | |
| IgG |
Product Content Correction
Your input is important to us. Please complete this form to provide feedback related to the content on this product.
Product Title
Spot an opportunity for improvement?Share a Content Correction